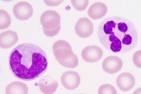

دانشکده پزشکی>گروه های آموزشی علوم پایه>خون شناسی و بانک خون
|
بسم الله الرحمن الرحیم
به صفحه اطلاع رسانی، آموزشی و پژوهشی
گروه خون شناسي و بانك خون
دانشکده پزشکی مشهد خوش آمدید
| ||||||||||||||||||
آدرس گروه: مشهد - خيابان احمد آباد - بیمارستان قائم (عج) - آزمایشگاه خون شناسی و بانک خون
تلفن : 8012584
تلفکس:8430493-0511
پست الکترونیک: sadeghianmh[at]mums.ac.ir
|